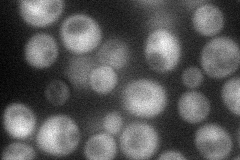
YER096W

View description
Sporulation-specific activator of Chs3p (chitin synthase III), required for the synthesis of the chitosan layer of ascospores; has similarity to Skt5p, which activates Chs3p during vegetative growth; transcriptionally induced at alkaline pH
Localization:
Intensity:
Fold change:
Significance:
-
C’ GFP library in SD

below threshold15.62 -
N' NOP1pr-GFP in SD
cytosol44.3177 -
N' TEF2pr-mCherry in SD

below threshold6.97096 -
N' NATIVEpr-GFP in SD

below threshold18.8334 -
N' TEF2pr-VC and Cyto-VN in SD

#N/A0 -
C’ GFP library in SD+DTT

cytosol18.431.17No -
C’ GFP library in SD+H2O2

cytosol16.751.07No -
C’ GFP library in Starvation Media

cytosol14.090.9No -
C’ GFP library on the background of Pup2-DaMP

below threshold -
C’ GFP library on the background of CCT mutant

below threshold17.66341.13021No
